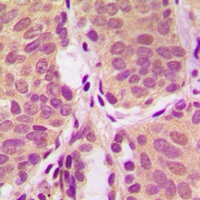
产品细节图片2

相关产品推荐更多 >

GCK Antibody - N-terminal region : Biotin 抗体,orb2096023,Biorbyt
¥8216
PSMD10 Antibody - middle region : HRP 抗体,orb2103311,Biorbyt
¥8216
SCAND2 Antibody - middle region : HRP 抗体,orb2100410,Biorbyt
¥8216
Bim Antibody (BF680) 抗体,orb1574637,Biorbyt
¥4796
C4orf20 Antibody - middle region : FITC 抗体,orb2102001,Biorbyt
¥8216
万千商家帮你免费找货
0 人在求购买到急需产品
- 详细信息
- 文献和实验
- 技术资料
- 抗体名:
PI3K p85 alpha Antibody抗体
- 抗体英文名:
PI3K p85 alpha Antibody
- 应用范围:
IF, IHC, WB
- 宿主:
Rabbit
- 适应物种:
Bovine, Human, Mouse, Rat
- 保质期:
6-12个月
- 抗原来源:
详询
- 目录编号:
orb216173
- 级别:
科研级
- 库存:
88
- 供应商:
biorbyt
- 标记物:
Unconjugated
- 克隆性:
Polyclonal
- 形态:
Liquid in 0.42% Potassium phosphate, 0.87% Sodium chloride, pH 7.3, 30% glycerol, and 0.01% sodium azide.
- 免疫原:
KLH-conjugated synthetic peptide encompassing a sequence within the center region of human PI3K p85 alpha. The exact sequence is proprietary.
- 规格:
30 ul
别名:GRB1; Phosphatidylinositol 3-kinase regulatory subunit alpha; PI3-kinase regulatory subunit alpha; PI3K regulatory subunit alpha; PtdIns-3-kinase regulatory subunit alpha; Phosphatidylinositol 3-kinase 85 kDa regulatory subunit alpha; PI3-kinase subunit p85-alpha; PtdIns-3-kinase regulatory subunit p85-alpha
免疫原:KLH-conjugated synthetic peptide encompassing a sequence within the center region of human PI3K p85 alpha. The exact sequence is proprietary.
应用稀释比例:WB: 1:500-1:1000, IHC-P: 1:100-1-200
纯化:The antibody was purified by immunogen affinity chromatography.
保存说明:Maintain refrigerated at 2-8°C for up to 2 weeks. For long term storage store at -20°C in small aliquots to prevent freeze-thaw cycles.
Entrez:25513, 5295, 18708
UniProt ID:P27986, P26450, Q63787
Note:For research use only.

风险提示:丁香通仅作为第三方平台,为商家信息发布提供平台空间。用户咨询产品时请注意保护个人信息及财产安全,合理判断,谨慎选购商品,商家和用户对交易行为负责。对于医疗器械类产品,请先查证核实企业经营资质和医疗器械产品注册证情况。
文献和实验signaling公司的Phospho-PI3K p85 (Tyr458)/p55(Tyr199) 我自己分析没有条带无非是细胞状态不好,或者抗体不好,不知道还有没有可能是没有加磷酸化酶抑制剂,以至于磷酸化的蛋白被去磷酸化了? 谢谢啦~ yhwangcams 检测内参蛋白如GAPDH,ACTIN,TUBULIN是否成功? 用PLB裂解细胞得到的蛋白适合做REPORTER,做WESTERN不太合适。建议可以用其他BUFFER裂解蛋白。
Nat Commun:结直肠癌致癌突变 RNF43_pG659fs 对 PI3K/mTOR 抑制剂敏感
标记进行定量蛋白质组学鉴定,结果发现 RNF43_p.G659fs 与 PI3K 调控亚基 p85 结合后将其泛素化降解,从而上调 AKT 的活性,提示 PI3K/mTOR 信号通路可做为 RNF43_p.G659fs 突变的治疗新靶点。 RNF43_p.G659fs 突变在微卫星不稳定 MSI 的患者中集中发生,但目前仍不清楚该突变和肿瘤免疫的关联。作者发现 RNF43_p.G659fs 与干扰素信号通路负相关,而且 PI3K/mTOR 抑制剂能逆转 p.G659fs 对干扰素信号通路的抑制
PI3K ― Akt 信号通路PI3K是一个复杂的大家族,根据其结构可分为3类:I型、Ⅱ型、Ⅲ型。 I型PI3K又分为IA和IB两个亚型,他们分别从酪氨酸激酶连接受体和G蛋白连接受体传递信号,其作用是催化磷脂酰肌醇(P1)在D3位的磷酸化,把底物PIP2转化为PIP3。IA型P13K是由催化亚单位Pll0和调节亚单位P85所组成的二聚体蛋白,具有类脂激酶和蛋白激酶的双重活性。在正常细胞中,P13K的活性是受许多机制严格控制的。一般认为,在静息细胞中,无活性的P85―P1lo复合物普遍
技术资料暂无技术资料 索取技术资料





